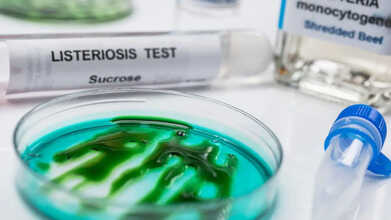
listeria pasta outbreak

- Health Conditions A-Z
- Health & Wellness
- Nutrition
- Fitness
- Health News
- Ayurveda
- Videos
- Medicine A-Z
- Parenting
- Web Stories
UK Children To Get Chickenpox Vaccine On NHS: Why It Is A Lifesaver Vaccine

Credits: Canva
From January next year, parents in England and Wales will have one less health worry on their checklist. The NHS is rolling out the chickenpox vaccine for free to all young children. Administered in two doses at 12 and 18 months, the jab will be paired with the existing MMR vaccine that already shields kids from measles, mumps and rubella.
The move also comes with a catch-up programme for slightly older children, ensuring no one misses out. It is a win not just for health but also for households and the economy, with chickenpox costing the UK around £24 million annually in lost workdays and productivity.
What is Chickenpox?
The virus behind it is the varicella-zoster, which spreads faster than playground gossip. It triggers an itchy rash, dotted with small blisters and often accompanied by fever, fatigue and general misery.
The rash, however, shows up 10 to 21 days after exposure and lasts about a week. And you can spread the virus even before the rash is evident and until every blister has dried out. That means kids can be carriers long before anyone realises.
Why the Vaccine is a Game-Changer
For most children, chickenpox is unpleasant but manageable. But in some cases, the virus does not play fair. Pregnant women, very young babies and adults are especially vulnerable. Complications can include pneumonia, encephalitis (brain swelling), bacterial infections, and in rare instances, even stroke. It sounds dramatic because it can be.
And let us not forget the dreaded shingles. Once you have had chickenpox, the virus hibernates in your nerve cells, waiting for years to reactivate. When it does, it emerges as shingles, a painful and sometimes long-lasting condition that haunts adults. By vaccinating children, the NHS is not just preventing itchy rashes; it is reducing future risks of shingles too.
Symptoms Worth Spotting
Chickenpox has a very distinct three stages:
- Red bumps called papules make their debut.
- Those bumps turn into fluid-filled blisters, which eventually burst.
- Scabs form and healing begins.
To complicate matters, new spots appear over several days, so your child may look like they are juggling different skin stages at once.
Who is at Risk?
Anyone who has not had chickenpox or the vaccine is fair game. The risk is higher for people working in schools, nurseries or any place where germs travel in packs. The virus can spread through direct contact with the rash or even via droplets from a cough or sneeze.
But if you have been vaccinated and still catch chickenpox, the symptoms are typically much milder: fewer blisters, less fever and a quicker recovery.
Complications That Keep Doctors on Their Toes
While chickenpox is usually mild, the potential complications are no joke. These include:
- Infected skin or bloodstream
- Dehydration
- Pneumonia
- Encephalitis
- Toxic shock syndrome
- Reye’s syndrome (when children take aspirin during infection)
Such risks say why the vaccine is not just a convenience but a lifesaver.
Tackling Falling Vaccination Rates
The chickenpox announcement also comes at a crucial time. Uptake of existing childhood vaccines in England is slipping. In 2024/25, none hit the 95 per cent target, with MMR uptake hovering at 91.9 per cent among five-year-olds—the lowest since 2010/11. Adding chickenpox protection to the routine schedule could help remind parents of the importance of immunisation.
Why Parents Should Welcome This Move
Chickenpox may sound like a rite of passage, but in reality, it is an unpredictable infection that can disrupt households, put vulnerable people at risk and occasionally turn dangerous. With the vaccine, parents can skip the sleepless nights of itch relief lotions, the endless laundry of pus-stained sheets and the nervous waiting for complications to pass.
Listeria Pasta Outbreak: Worried About Health Risks? Here’s How To Know If You Are Affected
Credits: CANVA
Recalled Pasta Meals Listeria: A nationwide listeria outbreak connected to recalled ready-to-eat pasta meals has claimed six lives and left several others hospitalized, according to the Centers for Disease Control and Prevention (CDC). Data shared by public health agencies, including the U.S. Food and Drug Administration (FDA) and the U.S. Department of Agriculture’s Food Safety and Inspection Service (USDA-FSIS), shows that 27 people across 18 states have been infected with the outbreak strain of listeria.
Out of 26 people with detailed medical information, 25 required hospitalization, and six deaths occurred in Hawaii, Illinois, Michigan, Oregon, Texas, and Utah. As reported by PEOPLE, one pregnancy-related infection also led to the loss of a baby.
The CDC noted that the real number of cases is likely higher since confirming a link to an outbreak can take several weeks, and some individuals may recover without medical attention.
As the listeria outbreak unfolds, it raises the question: how do you know if you are at risk?
Recalled Pasta Meals Listeria: Who All Are At Risks For Listeria Outbreak?
According to the CDC, listeria poses the greatest danger to pregnant women, adults over 65, and individuals with weakened immune systems. In these groups, the bacteria can spread beyond the intestines and cause a serious condition called invasive listeriosis.
- For pregnant women, infection can lead to pregnancy loss, premature birth, or severe illness in newborns.
- For older adults and people with compromised immunity, listeria often leads to hospitalization and, in some cases, death.
Other individuals may develop headache, stiff neck, confusion, loss of balance, and convulsions, along with fever, muscle aches, and tiredness.
Listeria Prepared Pasta Recall: How To Know If You Are Affected By Listeria
People usually get infected after consuming food contaminated with the bacteria. The incubation period, the time between infection and symptom onset, can range from 3 to 70 days, with an average of about 3 weeks. When a pregnant woman eats contaminated food, the infection can pass through the placenta to the baby.
As the CDC explains, healthy individuals may not show symptoms or might only develop mild, short-lived flu-like signs, sometimes with minor digestive discomfort. These mild infections typically remain limited to the gut lining.
In people at higher risk, the bacteria can spread into the bloodstream, leading to more severe complications. Older adults and those with weakened immune systems can develop meningitis or sepsis, which present as headache, stiff neck, confusion, loss of balance, or seizures.
Pregnant women may have few or no symptoms, but infection can still harm the baby, leading to miscarriage, stillbirth, premature labor, or meningitis in newborns. For more detailed information, pregnant women are advised to refer to official CDC guidance on listeria during pregnancy.
Recalled Pasta Meals Listeria: How Does Listeria Get Into Food?
Listeria monocytogenes is a naturally occurring bacterium found in soil and water. Vegetables may become contaminated through soil or manure-based fertilizers. Animals can also carry listeria without appearing sick, which means meat and dairy from these animals can be infected. In some cases, contamination occurs after food processing, such as in soft cheeses or deli products.
Listeria Prepared Pasta Recall: How Is Listeriosis Diagnosed?
Doctors typically confirm listeriosis by testing a patient’s blood or cerebrospinal fluid (the liquid that surrounds the brain and spinal cord). During pregnancy, a blood test is the most accurate way to determine whether a woman’s symptoms are caused by a listeria infection.
3 Lab Monkeys Escape in Mississippi In An Accident: What Were They Used For And Do They Pose Health Threat?

(Credit-Canva)
A group of research lab monkeys escaped captivity in Mississippi as the truck carrying them overturned on Tuesday. The monkeys were on their way to a Tulane University research center in New Orleans from the University’s Biomedical Research Center in Louisiana.
At first, officials worried the monkeys might have dangerous sicknesses, like herpes. However, Tulane University quickly said the animals were healthy and disease-free. They confirmed the monkeys had not been near any germ that could cause an illness.
Videos of the crash on Interstate 59 showed monkeys crawling in the grass next to broken wooden cages. So far, 14 monkeys have been found, 5 died, while 2 are still at large and the search continues. While the health officials assured people that there were no possible disease outbreaks, questions about ethical considerations and risks that come with animal testing have been brought up.
Why Are Monkeys Used In Medical Research?
According to the European Animal Research Association (EARA), scientists generally use animals like mice and rats much more than monkeys. However, monkeys, also called non-human primates (NHPs), are sometimes needed because their bodies are the most like human bodies. This means that for some diseases, mice and rats just aren't good enough models to show how a treatment will work in a person.
The Understanding Animal Research UK Organization explains that the most commonly used monkeys in research are Rhesus macaques, Cynomolgus macaques, and Common Marmosets.
Old-world monkeys, which are Macaques, share 94% genetic code with humans while the new-world monkeys which are Marmosets, share 91.7% genetic code with humans. The EARA expands that monkeys are especially important for research on:
- Brain diseases such as Alzheimer's and Parkinson's.
- Reproduction (like developing IVF).
- Infections where a person's body reacts very differently from a rodent's.
- New surgical techniques like organ transplants.
Even in Europe, which has strict rules to protect lab animals, experts agree that while the goal is to stop using monkeys completely, a limited number are still necessary right now for key studies on the immune system and brain diseases.
What Are The Risks Involved With Animal Research?
The Hastings Center for Bioethics explains that despite being used for research and discovering new treatments, almost 100 percent of new drugs for Alzheimer's have failed over many years. Some scientists point out that rhesus monkeys don't naturally get the full disease, the way humans do.
This brings up a moral question: Are we using these animals because science truly requires it, or is it simply the easiest option?
When animal research doesn't result in a cure for people, which is called a "translational failure", it means the lives of these conscious, feeling animals are wasted in experiments that probably won't work. This failure is also bad for humans, who face risks in trials based on weak animal data and who keep waiting for medical breakthroughs that never arrive.
Are Monkey-Based Researches Accurate?
The accuracy of these tests and research has been questioned before. According to a 2023 explainer published in the Nature, a scientist named Dr. Jonah Sacha, who studies the body's immune system and how it fights disease, bought a group of monkeys for his research on infectious diseases.
Before starting his studies, Dr. Sacha followed standard safety procedures and took chest X-rays of all the monkeys. This is like giving them a quick check-up. During this screening, he made a worrying discovery: one of the monkeys was sick.
This monkey was carrying the bacteria that causes tuberculosis (TB). Even though the monkey wasn't showing signs of being sick, the X-ray showed it had latent TB. "Latent" means the TB germs were hidden or sleeping inside its body, ready to cause the full, active disease later on. This finding was a major problem because TB is highly contagious and could have easily spread to the other monkeys, and potentially even to the lab workers, creating a dangerous situation.
The researchers explain that it can lead to disruptions in the experiments and unreliable data.
Can Monkeys Be Replaced For Research?
The EARA explains that monkeys are currently required to test new drug safety because no other animal or lab model, like "organs-on-a-chip," can fully replicate the human body's complexity. Banning these studies would simply move them outside the EU, as global safety rules demand them. For specific human diseases, especially in brain science, monkeys remain the only suitable model, and replacements are not yet ready.
Researchers are currently working on ways to remove the need for animals in health research, however overturning the status quo may take a few more years.
CDC Reports Six Deaths Tied To Listeria Outbreak In Packaged Meal Products

Credits: CANVA
A widespread listeria outbreak traced to contaminated ready-to-eat meals has resulted in at least six deaths and 27 hospitalizations across 18 states, according to the Centers for Disease Control and Prevention (CDC).
The Food and Drug Administration (FDA) has advised consumers to inspect their freezers for potentially affected items tied to the ongoing infections.
Nate’s Fine Foods, the company behind the products connected to the outbreak, issued a statement on September 29 confirming that listeria was found in some of its food products.
Listeria Outbreak Expands Across States, Linked to Ready-to-Eat Pasta Products
The number of deaths has increased in the ongoing listeria outbreak connected to ready-to-eat pasta dishes sold at major retailers including Walmart, Kroger, and Trader Joe’s.
According to the Food and Drug Administration (FDA), seven new cases of listeria infection have been confirmed in three additional states since the previous update on September 25. The outbreak has now affected 27 people across 18 states and caused six deaths as of October 30.
Of those infected, 25 required hospitalization, and one case involved a pregnancy-related loss, the FDA noted. The FDA, along with the U.S. Department of Agriculture (USDA) and the Centers for Disease Control and Prevention (CDC), continues to investigate the nationwide outbreak.
The investigation, which began in June, has traced the outbreak to contaminated precooked pasta produced by Nate’s Fine Foods, Inc. The tainted pasta was used in a variety of ready-to-eat items, including pasta salads, frozen meals, and deli products distributed through several major grocery chains.
What Is Listeria?
Listeria is a harmful bacterium that causes listeriosis, a serious infection spread through contaminated food. It is commonly found in soil, water, and various ready-to-eat items such as deli meats, soft cheeses, and prepackaged meals like the recently recalled pasta sold at Walmart.
Unlike most bacteria, Listeria can survive and multiply in cold environments, including refrigerators, which is why safe food storage and thorough cooking are essential, according to the Centers for Disease Control and Prevention (CDC).
Who Is Most at Risk from Listeria?
Although anyone can become infected, certain people face a greater risk of complications. These include pregnant women, newborns, older adults, and individuals with weakened immune systems. In pregnant women, the infection can lead to miscarriage, stillbirth, or severe illness in newborns.
Symptoms of listeriosis usually appear within two weeks of eating contaminated food. The illness often starts with digestive discomfort, including nausea or diarrhea, and can progress to more severe signs such as fever, muscle aches, headaches, stiff neck, confusion, and loss of balance.
Full List of Recalled Products Linked to Listeria Outbreak
According to The Associated Press, the following ready-to-eat meals have been recalled due to potential Listeria contamination:
- Sprouts Smoked Mozzarella Pasta Salad – sold from deli or Grab & Go section; best-by dates Oct. 10–29
- Giant Eagle Smoked Mozzarella Pasta Salad – expiration dates Sept. 30–Oct. 7
- Kroger Deli Bowtie and Penne Pasta Salads – sold Aug. 29–Oct. 2
- Scott & Jon’s Shrimp Scampi with Linguini Bowls (9.6 oz) – best if used by Mar. 12, 13, 17, and 21, 2027
- Trader Joe’s Cajun Style Blackened Chicken Breast Fettuccine Alfredo (16 oz) – best if used by Sept. 20, 24, 27, 28; Oct. 1, 3, 5, 8, and 10
- Albertsons Deli Pasta Salads – sell through dates Sept. 8–Oct. 4
- Marketside Linguine with Beef Meatballs & Marinara Sauce (12 oz) – best-by Sept. 22, 24, 25; Sept. 29–Oct. 1
- Marketside Grilled Chicken Alfredo with Fettuccine (12.3 oz) – best-by June 26 or earlier; (32.8 oz) – best-by June 27 or earlier
- Home Chef Chicken Fettuccine Alfredo (12.5 oz) – best-by June 19 or earlier
© 2024 Bennett, Coleman & Company Limited

